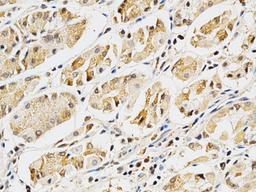
Immunohistochemistry - LGALS3 Antibody (A1464)

LGALS3 Rabbit pAb
Product Details
- Cat. No.
- A1464
- Type
- Primary Antibody
- Clonality
- Polyclonal
- Host
- Rabbit

The supplier does not provide quotations for this antibody through SelectScience. You can search for similar antibodies in our Antibody Directory.
Description
This gene encodes a member of the galectin family of carbohydrate binding proteins. Members of this protein family have an affinity for beta-galactosides. The encoded protein is characterized by an N-terminal proline-rich tandem repeat domain and a single C-terminal carbohydrate recognition domain. This protein can self-associate through the N-terminal domain allowing it to bind to multivalent saccharide ligands. This protein localizes to the extracellular matrix, the cytoplasm and the nucleus. This protein plays a role in numerous cellular functions including apoptosis, innate immunity, cell adhesion and T-cell regulation. The protein exhibits antimicrobial activity against bacteria and fungi. Alternate splicing results in multiple transcript variants.
Biological Information
- Clonality: Polyclonal
- Host: Rabbit
- Reactivity: Human, Rat